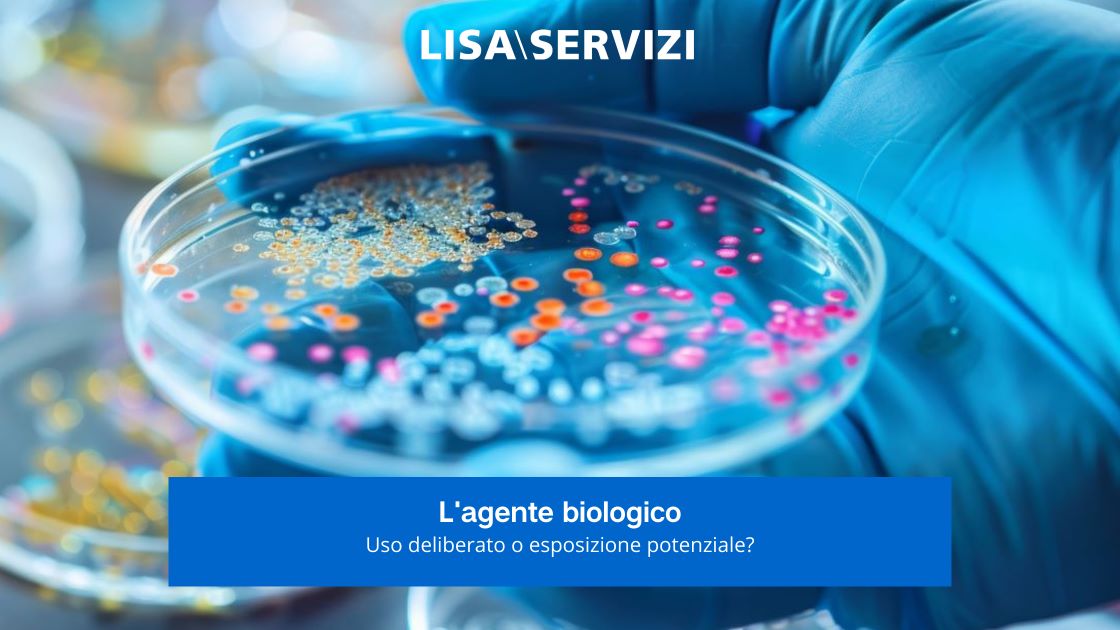
lagente-biologico-uso-deliberato-o-esposizione-potenziale

Un tecnico di laboratorio e un impiegato in un ufficio che si trova nella zona del porto marittimo.
Due mansioni con attività e procedure diverse tra loro, in luoghi di lavoro totalmente diversi ma legati da qualcosa. Che cosa?
Se andiamo ad analizzare nello specifico, dal punto di vista della salute e sicurezza e della valutazione dei rischi, tutti lavorano in un luogo dove potrebbero essere esposti al rischio biologico.
Certo, dobbiamo distinguere quando il rischio è specifico, e legato all’attività svolta con un uso deliberato di microrganismi, da quando il rischio è generico con esposizione potenziale.
Luoghi di lavoro in cui l’esposizione all’agente biologico è atteso
Infatti, l’uso deliberato presuppone operazioni dove gli agenti biologici sono presenti in quanto parte essenziale del processo (rischio atteso) e vengono introdotti intenzionalmente nel ciclo lavorativo per essere trattati, manipolati o trasformati ovvero per utilizzarne le proprietà biologiche.
Come per esempio accade nelle industrie alimentari, nelle aziende dell’agricoltura e della zootecnia, nei servizi sanitari, comprese le unità d’isolamento e le anatomie patologiche, nei laboratori clinici, veterinari e diagnostici, negli impianti di smaltimento rifiuti e di raccolta di rifiuti speciali potenzialmente infetti, negli impianti per la depurazione delle acque di scarico, e in tutte attività che ci indica l’Allegato XLIV del D. Lgs 81/08.
Esposizione potenziale all’agente biologico
Quando invece sono presenti attività dove gli agenti biologici determinano un evento “imprevisto” (rischio inatteso), si parla di esposizione potenziale e quindi di uso del microrganismo non deliberato e non diretto ad un vero e proprio uso nel ciclo lavorativo.
La valutazione del rischio biologico
Il datore di lavoro è tenuto a valutare il rischio per la salute dei lavoratori derivante dall’esposizione, anche potenziale, agli agenti biologici deliberatamente o occasionalmente presenti nell’ambiente di lavoro.
Ecco che è chiaro che il tecnico di laboratorio utilizza in modo deliberato agenti biologici, mentre l’impiegato o il manutentore sono esposti ad un rischio potenziale e, in questi casi, il rischio biologico non dipende quindi dal lavoro che svolgono, ma dall’ambiente in cui lavorano.
Sarà quindi importante analizzare quali attività, all’interno della stessa mansione, comportino una esposizione maggiore.
Per esempio, se un impiegato lavora in un ufficio, ma questo è situato in zone vicine al porto marittimo, potrebbe non esserci nessun rischio biologico all’interno dell’edificio ma nel percorso in entrata e uscita dell’azienda, la presenza di volatili potrebbe comportare la presenza e quindi l’esposizione ad agenti biologici che potrebbero portare ad una patologia.
Per tutti i lavoratori esposti al rischio biologico, con uso deliberato o meno dei microrganismi, è necessario che la valutazione consideri:
- modalità di esposizione del lavoratore;
- modalità di trasmissione dell’agente biologico e del suo eventuale ingresso nell’organismo umano;
- gravità degli effetti patologici sull’uomo dopo l’avvenuto contagio;
- frequenza del verificarsi dell’evento che può determinare il contagio;
- tempo di esposizione del lavoratore all’attività che può portare al contagio.
Per tutti i lavoratori sarà essenziale capire quali tipi di agenti biologici sono presenti e a quale classe appartengono per poter valutare il danno che potrebbero comportare; inoltre sarà essenziale vedere per quanto tempo e in quali occasioni i lavoratori sono esposti ad agenti biologici per valutare la probabilità che possa avvenire l’evento che comporta una patologia.
Tale analisi ci porta a valutare quindi il rischio biologico.
Misure di protezione e prevenzione contro il rischio biologico
Ma possiamo abbassare ulteriormente questo valore, arrivando ad ottenere un rischio residuo.
Questo è fattibile attraverso l’attuazione delle misure di prevenzione e protezione che il datore di lavoro è tenuto ad adottare.
Le misure di controllo, per esempio, nel caso del tecnico di laboratorio saranno strettamente legate alla sua mansione, mentre per l’impiegato, che lavora nello stabile al porto marittimo, saranno misure collegate all’ambiente e ai luoghi dove si possono trovare gli agenti biologici.
Potremmo quindi attribuire un valore ad ogni misura di prevenzione e protezione e valutare poi il suo impatto sul nostro rischio e quindi trarre il rischio residuo.
Per esempio, all’entrata dell’azienda situata nel porto marittimo potrebbero essere posti dissuasori per i volatili, predisposte procedure di pulizia delle zone esterne dell’azienda e altre misure di controllo.
Il valore finale ottenuto potrà quindi chiarire se il rischio residuo sia accettabile, rilevante, grave o molto grave e fornire indicazioni chiare su quali misure sono da ottimizzare o quelle che già sono attuate in modo efficace.
Lisa Servizi offre una valutazione del rischio biologico altamente personalizzata, con metodi di valutazione del rischio biologico specifici in base al processo produttivo e al tipo di esposizione presente.